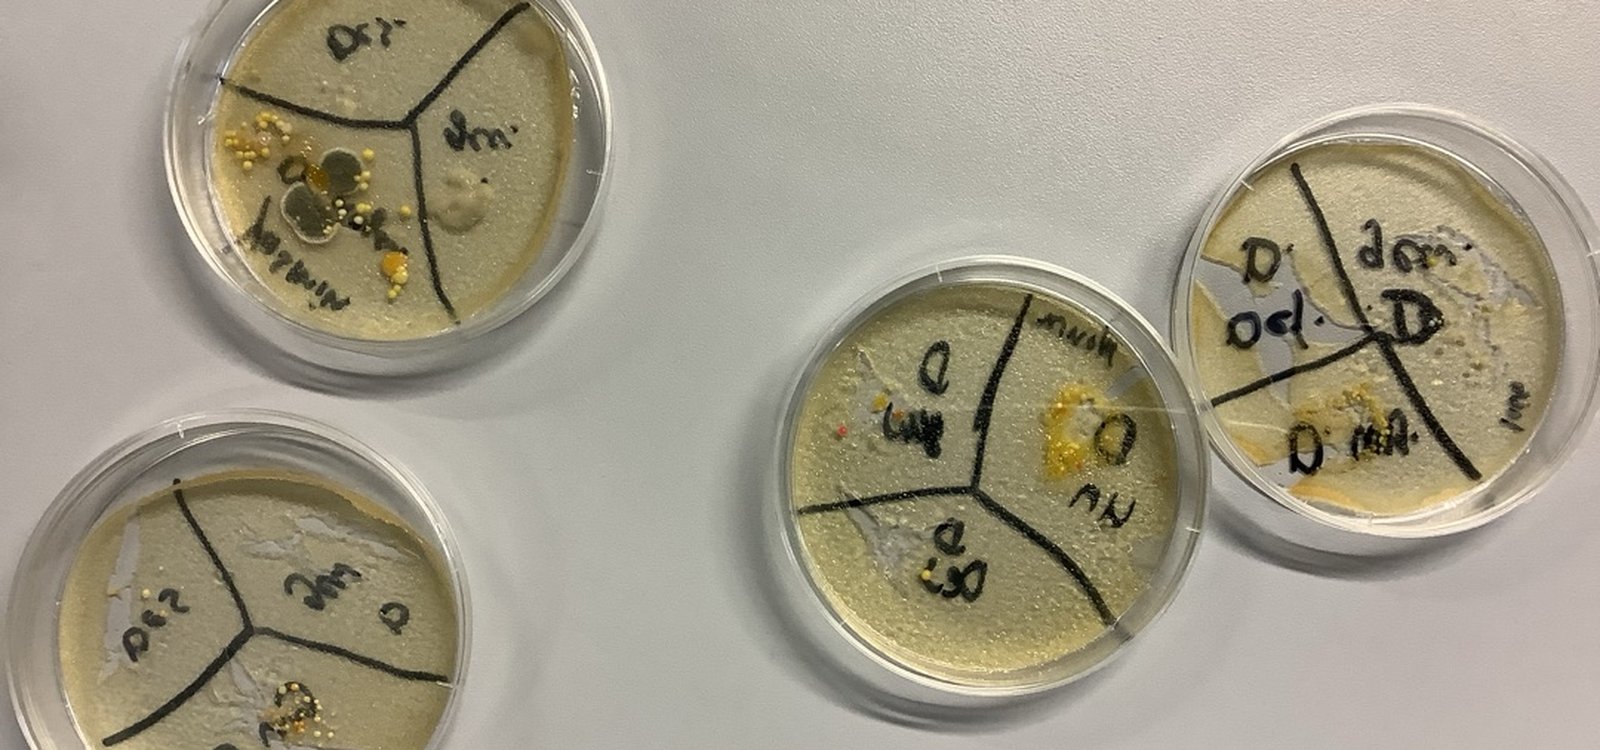

13 Feb. Sind saubere Hände wirklich sauber?
Sind Hände, die augenscheinlich sauber wirken, tatsächlich frei von Keimen? Mit dieser Fragestellung beschäftigte sich das Berufskolleg für Sozialpädagogik (BKSP) im Rahmen des Themas Hygiene.
Dazu führten die Schülerinnen und Schüler einen sogenannten Abklatschversuch durch. Mithilfe von Nährböden wurde sichtbar gemacht, wie viele Mikroorganismen sich auf ungewaschenen Daumen befinden. Das Ergebnis war eindeutig: Selbst scheinbar saubere Hände weisen eine Vielzahl von Keimen auf.
Im nächsten Schritt wurde untersucht, welche Wirkung gründliches Händewaschen mit Seife sowie die Anwendung von Desinfektionsmitteln haben. Dabei zeigte sich, dass bereits das Waschen mit Seife die Anzahl der Mikroorganismen deutlich verringert. Die stärkste Reduktion wurde jedoch durch die Verwendung eines geeigneten Desinfektionsmittels erreicht.
Der Versuch verdeutlichte anschaulich, wie wichtig eine konsequente und fachgerechte Händehygiene – insbesondere im sozialpädagogischen Arbeitsfeld – ist.
Lena Lich



